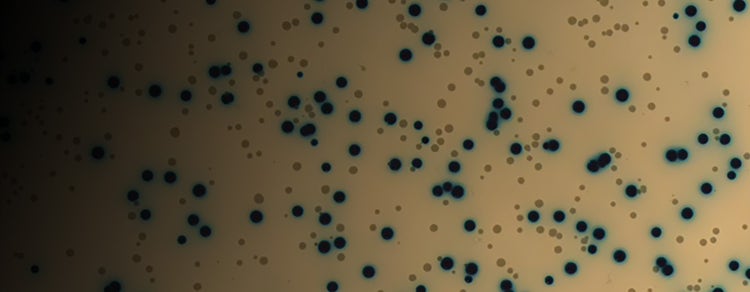

SCIENTIFIC POSTER
Automated Microbial Workflow from Colony to DNA
Explore an automated microbial workflow that integrates colony plating, picking, growth monitoring, and plasmid DNA quantitation to streamline strain screening and molecular biology workflows.

Automate Microbial Screening Workflows
Poster: Complete Microbial Workflow from Plating to DNA Quantitation
Microbial strain engineering and molecular cloning workflows often involve multiple manual steps, increasing the risk of variability and contamination.
This scientific poster demonstrates a fully automated microbial workflow that integrates colony screening, growth monitoring, and plasmid DNA quantitation.
In this poster, you will learn how researchers can:
- Automate plating, streaking, and colony picking using QPix® FLEX
- Select colonies based on morphology and blue/white phenotypes
- Monitor microbial growth kinetics in real time using OD600 measurements
- Evaluate nutrient or antibiotic responses during growth experiments
- Quantify plasmid DNA using fluorescence-based detection
- Combine colony screening and analytical workflows into a single streamlined process
Download the poster to see how automated microbial workflows accelerate molecular biology and synthetic biology research.
Heading
Download the Automated Microbial Workflow Poster
Product family
QPix
Product primary application
SpectraMax iD3 and iD5 Multi-Mode Microplate Readers; QPix FLEX Microbial Colony Picker; Agricultural Biotechnology; Cell Line Development; Drug Discovery and Development; Food & Beverage; Gene Editing (CRISPR/Cas9); Microbiomes; Molecular Cloning; Monoclonal Antibodies (mAbs); Monoclonality; Plasmid Production; Protein-Detection-Quantitation-and-Analysis; Synthetic Biology; Microbiology and Contaminant Monitoring; Nucleic-Acid-Detection-Quantitation-Analysis
CMP
701Nr00000tM7j8IAC
Title
Automated Microbial Workflow from Colony to DNA
Resource URL
Resource Image URL
